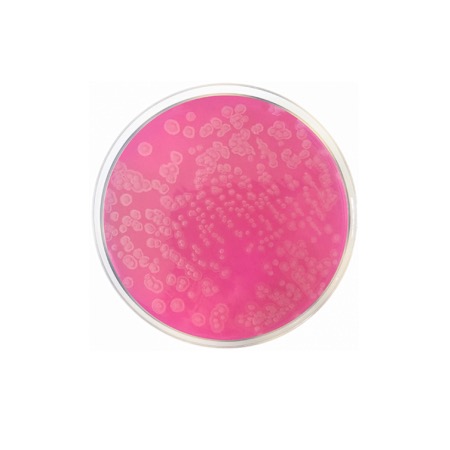

Acetamide Agar (Acetamide Medium) is formulated according to the standard procedures for the presumptive identification of Pseudomonas aeruginosa. The medium contains Acetamide, which serves as the unique carbon source. Bacteria capable of producing the enzyme acetamidase break down the acetamide, releasing ammonia as a byproduct. The production of ammonia increases the pH of the medium, causing the Phenol Red indicator to shift from a yellow-orange color to a deep pink or red. While P. aeruginosa typically gives a positive reaction, other non-fermenting Gram-negative bacteria usually fail to grow or do not change the color of the medium.
Advantages
- High Specificity: Excellent for the differentiation of Pseudomonas aeruginosa from other non-glucose fermenting bacilli.
- Clear Results: The vivid color change of the Phenol Red indicator makes interpretation straightforward.
- Standardized Formulation: Complies with internationally recognized methods for water and environmental testing.
- Selective Environment: The reliance on a single carbon source inhibits the growth of many non-target environmental bacteria.
- Minimal Ingredients: A simple but effective mineral-based formulation that ensures reproducible metabolic responses.
Technical specifications
| Catalogue number |
1391 |
| Brand |
Condalab |
| Application |
Identification of Pseudomonas aeruginosa |
| Typical Composition (g/L) |
Acetamide (10.0); Sodium Chloride (5.0); Potassium Dihydrogen Phosphate (1.0); Magnesium Sulfate (0.5); Phenol Red (0.012); Bacteriological Agar (15.0) |
| Final pH (at 25 °C) |
6.7 ± 0.2 |
| Preparation |
22.7 g/L |
| Storage Temperature |
2 – 25 °C |
Available packaging options
| 1391 |
500 g plastic bottle |